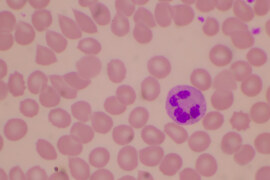

Akdeniz anemisi, hemoglobin üretiminde yer alan genlerdeki bozukluk nedeniyle ortaya çıkan kalıtsal bir kan bozukluğudur. Vücut yeterli miktarda sağlıklı kırmızı kan hücresi üretemediği için dokulara oksijen taşıma kapasitesi azalır. Bu ...
Anne Sözlüğü
Annelik yolculuğunuzda karşılaştığınız terimleri anlamakta zorlanıyor musunuz? Anne sözlüğü kategorimiz, hamilelikten başlayarak çocuk gelişimine kadar uzanan süreçte duyduğunuz tüm teknik terimleri ve bilinmeyen kelimeleri açıklayan kapsamlı bir rehber niteliğindedir. Özellikle yeni anneler için karmaşık gelebilecek tıbbi terminoloji ve uzmanlık gerektiren kavramları, günlük hayatta kullanabileceğiniz basit bir dille sizler için derledik.
Kistik Fibrozis Nedir? Anne Adayları için Bilmeniz Gerekenler

Kistik fibrozis, bazı ailelerde genetik olarak taşınan ve çocukları etkileyebilen bir hastalıktır. Adı belki biraz korkutucu gelebilir ama bu yazıda bu hastalığın ne olduğunu, belirtilerini ve nelere dikkat etmen gerektiğini ...
Braxton Hicks Kasılmalarının Özellikleri

Hamilelik sürecinde karşılaşılan en yaygın durumlardan biri olan Braxton Hicks kasılmaları, birçok anne adayının merak ettiği ve bazen endişelendiği bir konudur. Bu kasılmalar, rahmin doğuma hazırlanma sürecinde yaşanan normal fizyolojik ...
Surfaktan Nedir?

Bebekler için hayati önem taşıyan ve akciğerlerin sağlıklı çalışmasında kritik rol oynayan surfaktan nedir sorusunu yanıtlamadan önce, bu maddenin vücuttaki işlevini anlamak önemlidir. Surfaktan, akciğer alveollerinde bulunan ve solunum sisteminin ...
Mekonyum Nedir?

Yenidoğan bebeklerin ilk dışkısı olarak bilinen mekonyum nedir sorusu, özellikle yeni ebeveynler için merak konusudur. Bebeğin anne karnında oluşan ve doğumdan sonraki ilk 24-48 saat içinde atılan bu koyu renkli ...
Verniks Kazeoza Nedir? Ne İşe Yarar?

Bebeğinizin doğumunda cildi üzerinde gördüğünüz beyazımsı, krem benzeri tabaka olan verniks kazeoza, yeni doğan bebeklerin korunmasında önemli bir rol oynayan doğal bir maddedir. Anne karnında bebeğin cildini koruyan bu özel ...
Amniyosentez Testi Nedir? Riskleri Neler?

Amniyosentez testi, hamilelik sırasında bebeğin sağlığını kontrol etmek ve olası genetik hastalıkları tespit etmek amacıyla yapılan önemli bir prenatol testtir. Bu test, anne karnındaki bebeğin sağlık durumu hakkında kritik bilgiler ...
Linea Nigra Nedir? Hamilelikte Karında Beliren Koyu Çizginin Sebebi

Hamilelik sürecinde kadınların vücudunda birçok değişiklik meydana gelir. Bu değişikliklerden biri de linea nigra adı verilen koyu renkli bir çizginin ortaya çıkmasıdır. Bu çizgi, hormon seviyelerindeki değişikliklerin bir sonucu olarak, ...
Kolostrum Sütü Nedir? Faydaları Nelerdir?

Kolostrum sütü, bir annenin yeni doğan bebek için ürettiği ilk süt olarak bilinir. Bu özel süt, doğumdan hemen sonra salınır ve bebek için birçok faydayı beraberinde getirir. Senin de merak ...